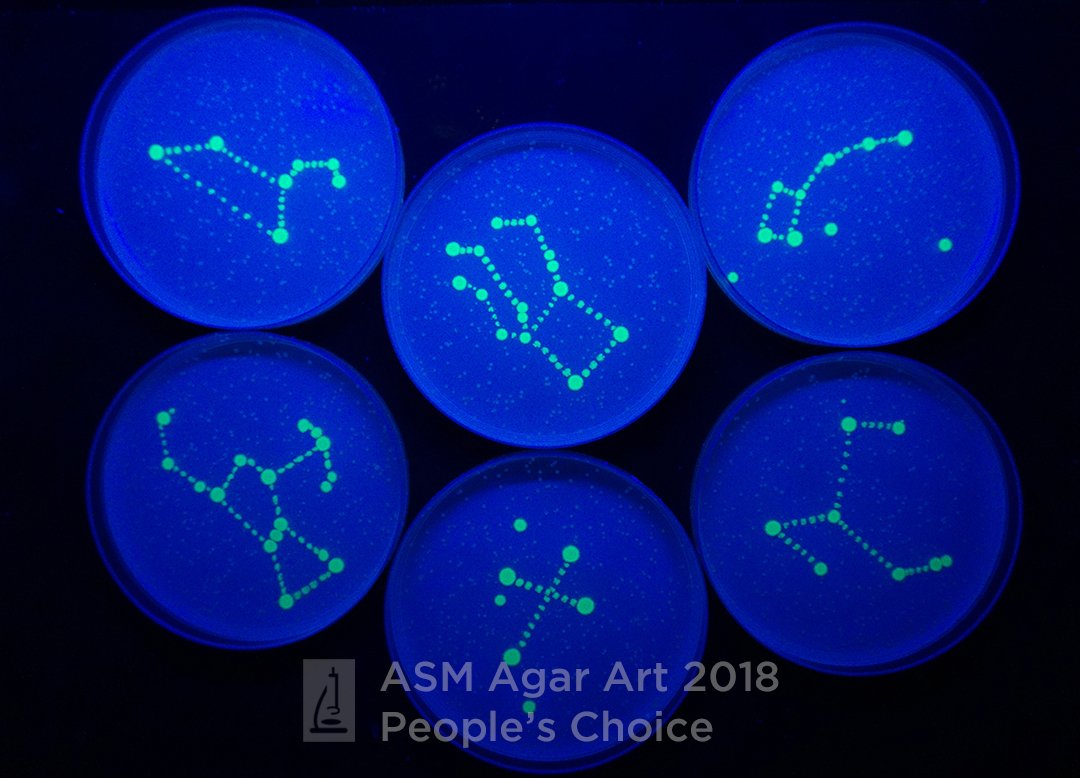
ASM tweet media

Jasmine Temple (she/her) retweetledi

Discover the world of bacterial art 🦠 🖌️ 🎨
Frankel et al. (@BosLabMA, @temple_jasmine @NEBiolabs) present an exploration of art created with living bacteria in #FEMSMicrobiolLett. A review about history, impact, and future of microbiology-inspired art.
academic.oup.com/femsle/article…

English